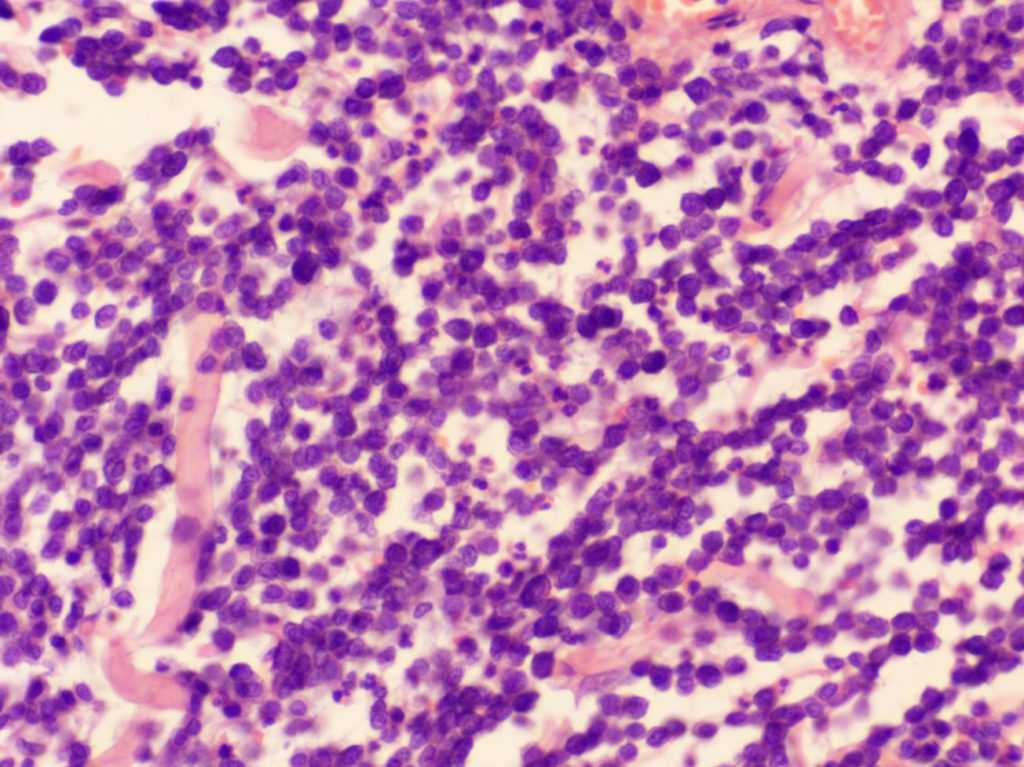

Какие бывают степени дифференцировки рака?
Показатель степени дифференцировки опухоли в онкологии принято обозначать латинской буквой G. Возможны пять вариантов:
- Gx — степень дифференцировки определить не удается.
- G1 — высокодифференцированные злокачественные новообразования.
- G2 — средняя степень дифференцировки.
- G3 — низкодифференцированные опухоли.
- G4 — недифференцированный рак. Опухолевые клетки утратили все внешние признаки и функции нормальных клеток. Они похожи друг на друга, как две капли воды, их единственными занятиями становятся рост и размножение.
Так выглядит общая схема, но для разных видов рака степень дифференцировки определяют по-разному. Например, во время осмотра под микроскопом опухолевой ткани из молочной железы учитывают наличие молочных канальцев, форму и размеры клеточных ядер, активность деления клеток. Каждый из трех признаков оценивают в баллах, затем подсчитывают их общее количество.
При раке простаты используют специальную систему Глисона. В ней предусмотрено 5 градаций, каждой из которых присвоено определенное количество баллов, в соответствии с нумерацией, от 1 до 5:
- В состав опухоли входят однородные железы, ядра клеток изменены в минимальной степени.
- В состав опухоли входят скопления желез, которые разделены перегородками из соединительной ткани, но расположены друг к другу ближе, чем в норме.
- В состав опухоли входят железы, имеющие разное строение и размеры, опухолевая ткань прорастает в перегородки из соединительной ткани и в соседние структуры.
- В состав опухоли входят клетки, которые сильно отличаются от нормальных. Опухоль прорастает в соседние ткани.
- Опухоль состоит из недифференцированных клеток.
Обычно рак простаты имеет неоднородное строение, поэтому врач должен выбрать из списка две градации, которые встречаются в большей части опухоли. Складывают баллы, по полученной цифре определяют степень дифференцировки.

Общие сведения
Что это такое? Фибросаркомы являются медленно растущими, злокачественными опухолями, чаще всего образующимися в соединительной ткани кожи и подкожной клетчатке. Опасность этого вида рака – его предрасположенность к рецидивам, даже при условии проведенной хирургической операции, химиотерапии или/и лучевой терапии. К счастью, случаев, когда эти новообразования давали бы метастазы, практически нет. Вообще, термин «фибросаркома» не слишком точен, так как в эту группу входит множество разновидностей рака. Нейрофибромы, опухоли оболочки периферических нервов (шванномы) и гемангиоперицитомы – все это «дружная семья», к которой относятся фибросаркомы.
Причина их возникновения неизвестна, но сегодня ученые много говорят о генетической к ним предрасположенности. Предрасполагающими факторами являются: радиация, курение хозяина собаки, инфекции, гормональные возрастные изменения. Ветеринарами выделяются также вакцинальная, ассоциированная фибросаркома мягких тканей у собак, но у этих животных они встречаются чрезвычайно редко и куда характернее для кошек. Этот тип опухолей чаще всего встречается у животных крупных пород. Особенно предрасположены старые кобели и животные среднего (пять-шесть лет) возраста. Опухоли часто поражают конечности. К сожалению, у собак довольно часто встречается агрессивная форма (для тех же кошек она нехарактерна), причем прогноз в этом случае сомнительный или неблагоприятный.

Вообще, что касается агрессивных, «быстрых» форм этого типа новообразований, выводы делать рано. Мы уже говорили о широкой номенклатуре новообразований, которые зачастую проходят в статистике как «фибросаркомы». Скорее всего, в этом случае уместнее говорить о гемангиоперицитомах. Эти опухоли образуются из перицитов, сосудистых клеток. В отличие от собственно фибросарком, они зачастую бывают не только злокачественными, но и имеют выраженную склонность к образованию метастазов. Путаница же в литературных источниках объясняется тем, что возможности диагностирования в ветеринарной практике не столь широки, как у медиков.
Впрочем, это не так важно. Какие симптомы могут указать на наличие новообразования? Сложно сказать, так как далеко не всегда опухоль бывает видна
Если она во рту, у собаки постоянно текут слюни, она плохо ест. При уходе можно обнаружить уплотнения на ее коже, в подкожном слое (на фото). При поражении лап конечность может разбухнуть из-за разрушения лимфатических протоков. На поздних стадиях наблюдается постоянная болевая реакция.
Самые распространенные виды раковой опухоли
Выживаемость при злокачественных опухолях зависит не только от стадии развития болезни, но и от локализации процесса. Давайте разберемся, какой рак излечим, и рассмотрим для примера самые часто встречающиеся варианты.
Рак молочной железы
Рак груди встречается у каждой десятой женщины в возрасте 60 лет. У мужчин патология регистрируется в 100 раз реже. Опасность этой опухоли напрямую зависит от ее типа:
- Эстрогензависимые образования содержат в своей структуре рецепторы к половым гормонам. Они хорошо реагируют на гормональную терапию. Чем лучше чувствительность опухоли, тем легче она отзовется на проведенной лечение – и тем выше шансы на выздоровление.
- Эстрогеннезависимые опухоли. Они не содержат нужных рецепторов и не поддаются гормональной терапии. Такие образования быстро распространяются в глубоко лежащие ткани и метастазируют.
Рак предстательной железы
До 95% всех злокачественных новообразований простаты – это аденокарциномы. Они формируются из железистого эпителия органа. По своей структуре опухоли неоднородны. Для оценки степени злокачественности новообразования используется шкала Глисона. Критерий диагностики – характер изменений структуры предстательной железы. Чем ниже дифференцировка клеток, тем агрессивнее рак – и тем хуже прогноз для пациента. Опухоль, по своей структуре схожая с нормальными клетками простаты, легче поддается излечению.
Теоретические шкала Глисона допускает отметку от 1 до 10 баллов. На практике низкие показатели (1 и 2 балла) говорят скорее о предраковых состояниях, а не об истинной злокачественной опухоли. 3-7 баллов по Глисону – это хороший прогноз. Если опухоль получила 8-10 баллов, она считается низкодифференцированной. Излечить такой рак довольно сложно.
Рак легкого
Злокачественная опухоль легких обычно выявляется на поздних стадиях. Специфика строения органа такова, что обнаружить болезнь на начальных этапах ее развития сложно. Карцинома успешно маскируется под другие заболевания легких и зачастую обнаруживается только в III-IV стадии.
Прогноз при новообразованиях легких зависит от формы патологии. Наиболее опасен недифференцированный мелкоклеточный рак. Он отличается скрытым течением, быстрым ростом и метастазированием. Медленнее всего развивается дифференцированный плоскоклеточный рак, и при его выявлении шансы на выздоровление высоки.
Симптоматика
На скрытом этапе течения заболевания симптоматика отсутствует.
Первые симптомы появляются из-за разрастания опухоли:
- Боль в той зоне, где локализуется новообразование;
- Наличие сгустков крови;
- Появление запоров;
- Рост лимфатических узлов;
- Потеря в весе;
- Снижение гемоглобина;
- Утомляемость;
- Низкая трудоспособность;
- Плохой сон.
На стадии интенсивного роста раковых клеток и появления метастазов выраженность симптомов усиливается.
Разберем симптоматику при формировании аденокарциномы в различных органах.
Кишечник
- Болезненный живот;
- Неприятные ощущения после приема пищи;
- Плохая проходимость кишечника;
- Жидкий стул, чередующийся с запорами;
- Кровь и слизистые выделения в кале.
Полость носа
- Отек миндалин;
- Не проходящее воспаление миндалин;
- Боли в гортани, глотке, носу;
- Неприятные ощущения при глотании;
- Боль в ушах;
- Нарушение речи;
- Увеличение лимфоузлов.
Другие статьи по теме:
- Кратковременные отключения сознания
- Выездные консультации и исследования
- Диагностика и лечение эпилепсии
- Направления деятельности
- Заболевания
- Болезнь Паркинсона, паркинсонизм и другие экстрапирамидные патологии
- Лечение головокружений
*Материалы, размещенные на данной странице, носят информационный характер и предназначены для образовательных целей. Посетители сайта не должны использовать их в качестве медицинских рекомендаций. Определение диагноза и выбор методики лечения остается исключительной прерогативой вашего лечащего врача! Клинический Институт Мозга не несёт ответственности за возможные негативные последствия, возникшие в результате использования информации, размещенной на сайте neuro-ural.ru.
Причины возникновения у собак
Точных причин, почему возникают мастоцитомы, до сих пор не выявлено. Считается, что процесс связан с генетической мутацией в некоторых клетках. Такие нетипичные структуры начинают бесконтрольно делиться, в результате чего увеличивается объем ткани, где они находятся.
В ходе исследования болезни, выявлено что:
- Мастоцитома у собак может развиваться в любом возрасте, но средний около 9 лет.
- Половой предрасположенности нет, болеют и кобели, и самки.
- Заболевание не передается по наследству.
- Породная предрасположенность: более склонны к развитию новообразований бостон-терьеры, питбультерьеры, ретриверы.
- Высокозлокачественные опухоли встречаются у шарпеев, особенно в молодом возрасте.
- У боксёров и мопсов в большинстве случаев образования доброкачественные.
Куда обратиться при аденокарциноме толстой кишки
Чтобы пройти скрининг, диагностику и лечение аденокарциномы толстой кишки, обратитесь в клинику СОЮЗ. Наши преимущества:
- Точная диагностика, позволяющая обнаружить даже опухоли минимального размера.
- На ранних стадиях аденокарциномы кишечника возможно удаление злокачественных опухолей эндоскопическим доступом, без разрезов на животе.
- По возможности для лечения рака предпочтение отдается лапароскопическим операциям – малотравматичным вмешательствам через короткие разрезы на животе («хирургия замочной скважины»).
- Для рассечения тканей используются электрохирургические и ультразвуковые инструменты, которые быстро коагулируют сосуды и уменьшают кровопотерю.
- Возможность проведения даже самых сложных хирургических вмешательств, включая лечение 4 стадии или рецидивов рака кишечника.
- Индивидуальный подбор медикаментозного лечения на основе молекулярно-генетических анализов.
- Щадящее паллиативное лечение терминальной стадии рака: стентирование кишечника, эндоскопическая остановка кровотечений, малоинвазивные операции по восстановлению проходимости толстой кишки, устранение асцита (жидкости в брюшной полости).
Лечение депрессии — как с ней бороться?
Терапия определяется психиатром или психотерапевтом. Чаще всего основа для лечения депрессии — адекватная фармакотерапия, предусматривающая более 1 препарата из-за сложности клинических проявлений. Часто пациенты, борющиеся с депрессией, также мучаются из-за бессонницы, тревожности и соматических симптомов, например, одышки, частых головных болей.
Существует множество терапевтических направлений, которые назначаются в зависимости от расстройства и включают когнитивно-поведенческую терапию, психосоматическую терапию, гештальт и т.д. Антидепрессанты иногда не способны решить все симптомы депрессии. Именно поэтому так важна трудовая или индивидуальная терапия.
Причины аденокарциномы толстой кишки
Точные причины аденокарциномы толстой кишки у одного отдельно взятого пациента установить обычно нельзя. Вероятность этого заболевания повышают такие факторы риска:
- ожирение;
- низкая физическая активность;
- питание с избыточным потреблением красного мяса, жареной еды, низким содержанием в рационе фруктов и овощей;
- гиповитаминоз D;
- курение;
- злоупотребление алкоголем;
- возраст старше 50 лет;
- отягощенная наследственность 30% больных имеют ближайших родственников с раком кишечника в анамнезе.
У многих пациентов аденокарцинома появляется на фоне полипов толстой кишки. Для снижения риска заболевания их необходимо удалять. Риск патологии также увеличивает болезнь Крона и неспецифический язвенный колит. 5% случаев заболевания развиваются из-за наследственных синдромов.
Как распознать мастоцитому у животного?
Мастоцитомы по клинической картине являются великими имитаторами. Они могут быть в виде язвочек, припухлостей, бляшек, рыхлых подкожных масс, что может привести к ложному заключению. Однако диагноз поставить в большинстве случаев не представляет трудности. Путем тонкоигольной биопсии проводится забор клеточного материала, из которого далее делается мазок и красится по Паппенгейму.
 Получение материала для цитологического исследования из внутрикожного образования методом тонкоигольной аспирационной биопсии
Получение материала для цитологического исследования из внутрикожного образования методом тонкоигольной аспирационной биопсии
Около 90% мастоцитом имеют характерный вид при световой микроскопии. В противном случае, приходится проводить окрашивание биопсийного материала толуидиновым синим, который позволяет отдифференцировать гранулы биологически активных веществ в цитоплазме. Однако у кошек нечасто, но встречаются опухолевые мастоциты без внутриклеточного гранулярного компонента, так называемый гистиоцитарный тип мастоцитомы. В этом случае необходимо проведение иммуноцитохимии или иммуногистохимии. Также для полного понимания биологического поведения новообразования у конкретного животного необходимо проведение анализа на C-Kit и Ki-67. Эти два показателя являются ведущими для оценки чувствительности опухоли к химиотерапии и для прогноза течения заболевания. Цитологический анализ позволяет быстро и дешево поставить диагноз, и в этом его плюс. Но степень злокачественности определяется только на основании проведения патогистологического исследования, либо биопсийного материала.
 Цитология
Цитология Гистология
Гистология
У собак заболевание протекает всегда изолированно, то есть каждый очаг – это отдельная опухоль, растущая независимо от других. У кошек же один или несколько мастоцитом зачастую являются результатом системного заболевания. Но в любом случае животное подвергается комплексному обследованию.
 Клиническая картина мастоцитом
Клиническая картина мастоцитом  Клиническая картина мастоцитом
Клиническая картина мастоцитом
Лечение в клинике «Энергия здоровья»
Врачи клиники «Энергия здоровья» всегда готовы принять пациента любого возраста. Мы проведем тщательное обследование, выявим возможные причины энцефалопатии и примем все меры по ее устранению:
- назначим наиболее подходящую терапию, распишем курс лечения и частоту его повторения;
- проведем все необходимые манипуляции (постановка капельницы, внутривенные и внутримышечные инъекции) в комфортабельных условиях дневного стационара и манипуляционного кабинета;
- дополним терапию современными физиотерапевтическими процедурами;
- проведем курс массажа и назначим ЛФК для максимальной эффективности.
Наши неврологи будут контролировать состояние пациента и корректировать лечение при необходимости. Лечение энцефалопатии – это длительный и сложный процесс, но мы готовы за него взяться.
Папилломатоз
Вирусный папилломатоз – заболевание, которое в последнее время все чаще диагностируется у собак. Это доброкачественное новообразование, которое очень часто заканчивается самостоятельным выздоровлением животного. Однако не стоит недооценивать папилломатоз, так как он может передаваться другим собакам, при недостатке лечения трансформируется в злокачественную опухоль. Велик риск также получить и дополнительную инфекцию, если собака случайно повредит «бородавку».
Симптомы
Папилломатоз обычно развивается у собак в ротовой полости в период от 1 до 4 лет. Первые «бородавки» появляются в области губ и постепенно разрастаются далее в полости рта и глотки. Изначально папилломы имеют светло-розовый цвет и округлую форму, но затем превращаются в неровные, похожие на цветную капусту образования. Иногда их всего две-три, но обычно они постепенно покрывают всю слизистую оболочку полости рта.
Папилломатоз может появиться также на щеках собаки, веках, кожных покровах. В отдельных случаях «бородавки» вырастают даже вокруг носа или около пищевода. Иногда огромное количество папиллом даже мешает собаке нормально есть и пить, спокойно закрыть рот. Травмируются они очень легко, что влечет за собой возможное дополнительное инфицирование животного болезнетворными микроорганизмами.
Лечение
Папилломатоз обычно проходит сам в течение нескольких месяцев, но в отдельных случаях может потребовать и лечения. Как правило, сначала ветеринары пробуют применять терапевтические методы, то есть введение аутогенных вакцин. Папилломы удаляются хирургически обычно в том случае, если слишком разрослись и мешают собаке нормально есть и пить. Одно время для лечения заболевания в США применяли химиотерапию, обычно в тех случаях, если новообразования не исчезали сами долгое время. Кстати, хирургический метод применяют достаточно редко, так как велик риск, что папилломы могут распространиться еще больше.
Папилломатоз — заболевание развивающееся на фоне снижения иммунитета. Поэтому в основном лечение требует применение иммуностимулирующей терапии.
Последнее время все чаще для лечения этого заболевания в ветеринарии применяются иммуномодуляторы, например, Лигфол. Папилломы разрастаются обычно, если иммунитет у собаки ослаблен. Лигфол – это раствор для инъекций, содержащий гидролизный окисленный лигнин. Препарат применяется в ветеринарии с 1995 года.
Лигфол – это прекрасный стимулятор иммунитета, который повышает сопротивляемость организма к различным заболеваниям. Препарат зарекомендовал себя и как отличное противоопухолевое средство. Лигфол воздействует на новообразования, уменьшая их и постепенно разрушая. Также он способствует восстановлению поврежденных тканей.
Инъекции препарата будут полезны и в том случае, если папилломы были удалены. Но ветеринары отмечают, что уколы Лигфола могут причинить собаке боль. Помимо иммунотерапии при папилломатозе используют лечение новокаином, который вводят внутривенно. Как вылечить папилломы народными средствами – рассказано в видео.





























